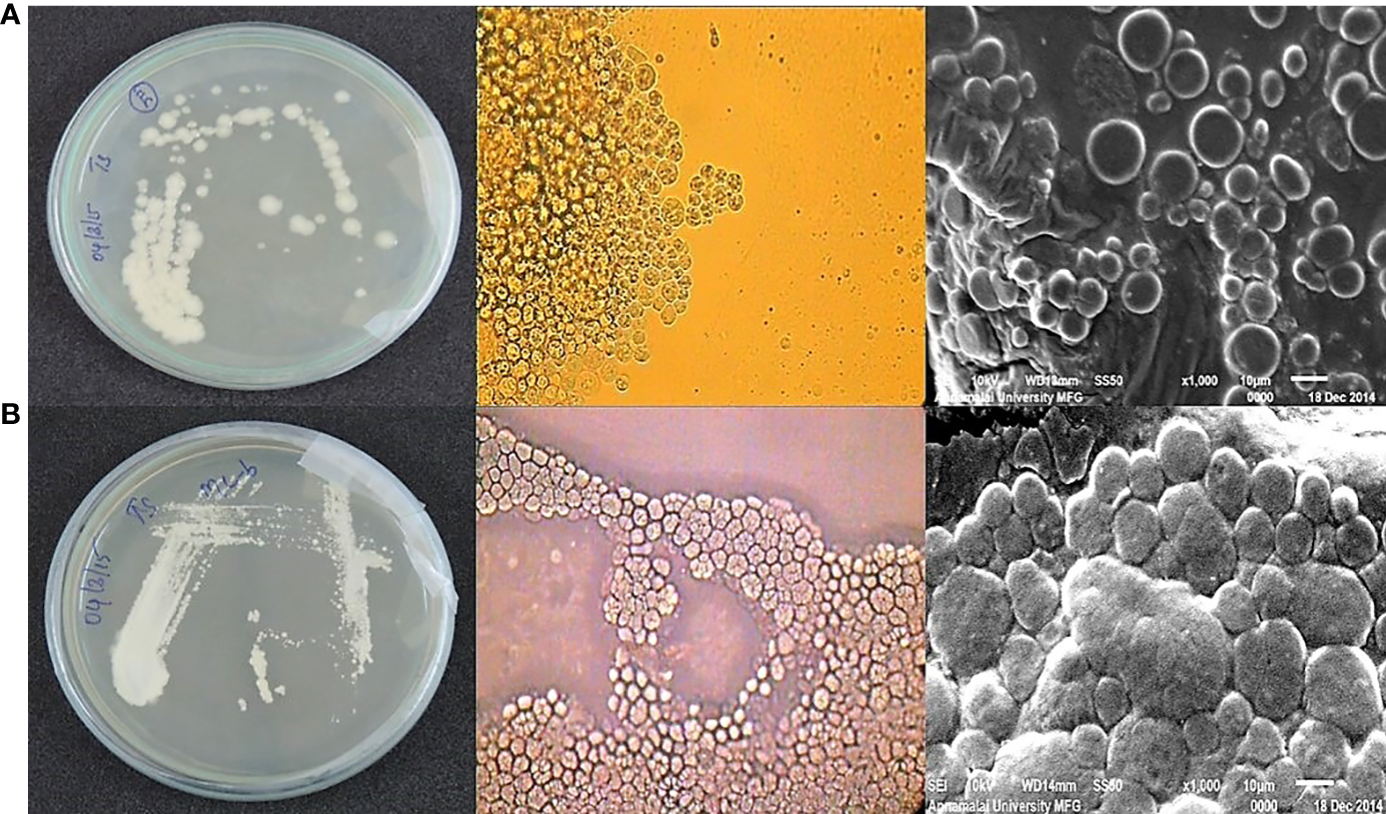

Abstract
Thraustochytrids contribute to the microbiota of mangrove ecosystem, and they hold promise as a potential source of polyunsaturated fatty acids (PUFAs), antimicrobials and antioxidants for their application in pharmaceutical, aquaculture, and human health sectors. However, the thraustochytrids have not been properly studied in Indian mangrove ecosystems for their PUFAs and biological activities, and hence, the present study was carried to isolate the PUFAs-rich thraustochytrids for their pigments, antimicrobial and antioxidant properties. This work isolated and identified the thraustochytrids that are capable of producing PUFAs from decomposing leaves of mangroves at Pichavaram, southeast coast of India. Two predominant isolates were identified as Thraustochytrium sp. and Aurantiochytrium mangrovei based on morphological and molecular characteristics. Thraustochytrium sp., produced the biomass of 4.72 g L-1, containing total lipids of 42.36% and docosahexaenoic acid (DHA) of 32.69% of total lipids, whereas, A. mangrovei produced the biomass of 6.25 g L-1 containing total lipids of 49.81% and DHA of 44.71% of total lipids. Astaxanthin pigment accumulated up to 3.2 µg L-1 in A. mangrovei, whereas the pigment was not detected in Thraustochytrium sp. Further, the biomass extracted in organic solvents was tested for antibacterial activity against seven clinical pathogens along with positive control of ampicillin. Thraustochytrium sp., exhibited the highest antibacterial activity with the zone of inhibition of 78.77% against Staphylococcus aureus and the lowest (20.95%) against Klebsiella pneumonia. Thraustochytrium sp., also showed minimum inhibitory concentration (MIC) of 40 µg L-1 inhibiting the growth of S. aureus. The antioxidant activity of A. mangrovei was tested by using six assays and noted the highest free radical scavenging (87.37 ± 1.22%) and the lowest nitric oxide radical scavenging (75.12 ± 2.22%) activities. Hence, it is clear that the extracts of Thraustochytrium sp., and A. mangrovei are promising sources of lead compounds for biopharma and food industries.
Introduction
Thraustochytrids are unicellular oleaginous, eukaryotic-stramenopile protists under the kingdom-Stramenopiles, and they comprise oomycetes and diatoms (Bongiorni, 2012; Dellero et al., 2018). The thrastochytrids were initially classified based on the presence of biflagellated zoospores (Huang et al., 2003), and later based on morphological characters, molecular sequence studies, polyunsaturated fatty acids, and pigment profiles. There are 11 genera and 35 species under Thraustochytriaceae, and more than 15 species belong to Thraustochytrium sp., (Kalidasan et al., 2021b). They are abundantly present in coastal water and estuarine habitats especially algae, plants, detrital water and sediments, including decaying mangrove leaves (Marchan et al., 2018; Wang et al., 2019). The thraustochytrids are primary decomposers, playing a significant role in nutrient recycling and in provision of food to detritus-feeding organisms in mangrove habitats by decaying litter (Raghukumar, 2002; Kathiresan et al., 2011; Taoka et al., 2017).
Thraustochytrids are known to secrete a variety of hydrolytic extracellular enzymes such as amylases, protease, cellulase, lipase, pectinase, esterase, and phosphatase (Taoka et al., 2009; Taoka et al., 2017; Lin et al., 2020). They contribute significantly to the carbon cycle in coastal waters by decomposing organic substrates such as cell walls and phenolic compounds such as tannins (Raghukumar, 2017). They enrich nutrients and enhance soil fertility in mangrove and estuarine environments (Kathiresan et al., 2014; Kalidasan et al., 2019). The thraustochytrids are also capable of synthesizing nanoparticles (Kalidasan et al., 2021a) with antimicrobial and antioxidant properties (Kalidasan et al., 2015a; Kalidasan et al., 2015b; Kalidasan et al., 2021b; Kalidasan et al., 2022).
Thraustochytrids are able to produce a membrane extension called the ectoplasmic network. When grown in nutrient- deficient conditions, this network is more extensively produced to facilitate nutrient absorptions directly from the surrounding environment (Hamamoto and Honda., 2019). The ectoplasmic nets recognize the food source by adhering to it and become thicker, during which secretion of digestive enzymes and absorption of digested substances take place (Iwata and Honda, 2018). The ectoplasmic net requires phospholipids, which are produced at the expense of triacylglycerols or a neutral lipid in the cells of thraustochytrids (Jain et al., 2007; Raghukumar, 2017). The docosahexaenoic acid (DHA) is helpful as a quick energy source during starvation. As a result, DHA gets decreased during the starvation of thraustochytrids and provides energy during their mobile life stages (Jain et al., 2007).
Thraustochytrids are a promising source of fatty acids, notably omega-3 PUFAs such as eicosapentaenoic acid (EPA) and DHA (Raghukumar, 2008; Pawar et al., 2021). These fatty acids are important for aquatic ecological processes, and as essential nutrients for fishes (Song et al., 2015; Ye et al., 2015). Crustacean zooplankton require the fatty acids for their growth and reproduction as they possess a limited or no ability to synthesize the fatty acids (Nichols and Nichols, 2008). Thraustochytrids are used to enhance the PUFA content of rotifers and Artemia that serve as live food for marine fish larvae which need more DHA than EPA in their diets (Barclay and Zeller, 1996; Castillo et al., 2009) resulting in increased survival rate of fish larvae (Sprague et al., 2015). Recently, DHA and EPA have garnered attention because of their pharmacological and nutritional properties, such as enhancing brain and retina development (Ratledge, 2004), hypertension reduction (Boyer-Diaz et al., 2020), anti-cardiovascular (Liao et al., 2022), and anticancer activities (Kalidasan et al., 2022). Hence the culture of PUFA-producing thraustochytrids has gained prominence for supply of PUFA-rich biomass and oils (Raghukumar, 2008; Raghukumar, 2017; Pawar et al., 2021). Currently, fish and fish oils are major sources for the production of DHA. However, the fish oil contains a low level of DHA and large-scale production of the DHA from the fish oil is difficult (Kalidasan et al., 2021b). In the context of the over-exploitation of fish stock and declining fish populations, the DHA demand and supply flow chain are disturbed (Liang et al., 2022). The omega-3 PUFA market is valued at approximately 4.3 billion USD in 2019 (Aasen et al., 2016). The fatty acid profiles of microbes are stable, safer and renewable vegetarian oil which is a suitable alternative source for DHA production (Mariam et al., 2021) with wide range of commercial utility in the pharmaceutical and nutraceutical, industries (Paliwal et al., 2019).
Thraustochytrids have been investigated in various coastal, estuarine, and mangrove environments in different countries: China (Mohan et al., 2022), Vietnam (Hien et al., 2022), Thailand (Aini et al., 2022), Japan (Taoka et al., 2017), Sweden (Patel et al., 2021), Italy (Russo et al., 2021), Korea (Saini et al., 2023), and Taiwan (Chauhan et al., 2023). However, only a limited number of Indian mangrove areas is studied for thraustochytrids from Goa (Raghukumar, 2017), Kerala (Jaseera et al., 2018), Mumbai (Pawar et al., 2021), Andaman Islands (Kalidasan et al., 2021b), and Tamil Nadu (Kalidasan et al., 2021a). In spite of extensive occurrence, the marine thraustochytrids are only poorly understood for their biomass, PUFA, carotenoid production and biological activities from Pichavaram mangrove area. Hence, the current study was made on isolation, identification, and characterization of mangrove-derived thraustochytrids, in addition to optimization of culture conditions for production of biomass, PUFAs, carotenoid and biological activities.
Materials and methods
Collection and processing of mangrove leaves
The senescent mangrove leaves (SML) of Rhizophora mucronata Poir., and R. annamalayana Kathir., were sampled from Pichavaram mangrove habitats (Lat. 11° 25’ 38.4 N, Long. 79° 47’ 35.5 E),, situated along the southeast coast of India. The SML were transferred to the research laboratory in a sterile zip-lock cover, and they were kept at 4°C until further processing.
Isolation, screening, and maintenance
SML were cleaned with sterile natural seawater (NSW) and then used for isolation of thraustochytrids by direct plating method (Kalidasan et al., 2019; Kalidasan et al., 2021b; Kalidasan et al., 2022). The SML were then cut aseptically into 0.5 cm2 fragments and transferred to a Petri dish having NSW with antimicrobial (ampicillin 100 µg L-1, streptomycin sulfate 50 µg L-1), and antifungal (fluconazole 150 µg L-1) agents (Himedia, Mumbai). SML samples were placed on culture medium comprising of glucose (5 g L-1), peptone (2.5 g L-1), yeast extract (1.25 g L-1), and agar (12 g L-1) (GPYA) in NSW with the addition of antifungal and antibacterial agents to avoid contaminations, and the plates were incubated at 30°C, pH 7.2 for 24 hrs. After the incubation, the culture plates were observed daily for 2-7 days using a bright field microscope (Nikon Eclipse Ni-U microscope, Nikon Corporation, Tokyo, Japan). Thraustochytrids were observed as cream oily, pale white, pale orange colour with smooth, rough, and uneven surface and then were aseptically sub-cultured to fresh agar medium. Further, the plates were checked on a daily basis for growth, development, and contamination of colonies (Figure 1). The pure colonies of the mother cultures were cryopreserved at -80°C as 20% glycerol stock for future use.
Figure 1

Thraustochytrids isolation, screening, and purification process.
Morphological and microscopical identification
Morphological identification of thraustochytrids, including colour and shape was made during the development of the life cycle, such as the presence of vegetative cells, ecto-plasmic network, cluster formation, binary division, zoospores, and amoeboid cells under the light microscope. A scanning electron microscopy (SEM) technique, as described by Kalidasan et al., 2021b, was used for further analysis. The freeze-dried thraustochytrid cells were put on a glass slide, fixed with 2.5% v/v glutaraldehyde at 4°C for 2 h, and then washed thrice with 0.1 M sucrose in 0.1M cacodylate buffer, pH 7.2 for 4 min 30 sec. The specimen was post-fixed with 2% OsO4 at retention time for 1 hr 30 min under the flow-hood, followed by three washes with distilled water lasting for five minutes each. After fixation, the samples were dehydrated with varying grades of ethanol (10, 20, 40, 60, 80, 90, and 100%), and then isoamyl acetate was substituted. CO2 was used to dry the mounted samples after they were transferred to carbon tape on an aluminium stub. Following the application of a surface gold coating, the samples were examined using a SEM instrument (JSM-IT500, JEOL InTouchScope™ Tokyo, Japan).
Molecular identification by 18S rRNA gene sequence analysis
The molecular identification of thraustochytrids was performed using the method as described by Mo and Rinkevich (2001), with some changes. Five mL of 48-hour-old cell culture was centrifuged at 12,000 × g at 4°C for 5 minutes. The cells were collected and resuspended with 200 µl of lysis buffer (0.1 M EDTA, 0.25 M Tris-HCl; pH 8.2), 0.1 M NaCl, 2% sodium dodecyl sulfate, and then kept in a water bath at 55°C for 65 min for homogenization. DNA was then extracted in chloroform - isoamyl alcohol and precipitated by chilled isopropanol. The purified DNA was dissolved in 30 µl of TE buffer and stored at -20°C for until use. The gene was amplified using primers (18S001-5’-AACCTGGTTGATCCTGCCAGTA-3’, and 18S13-5’-CCTTGTTA CGACTTCACCTTCCTCT-3’) obtained from previous literature (Honda et al., 1999). Additionally, a molecular weight marker was used to determine the molecular weight (100 bp ladder). The amplicons were examined by electrophoresis on 1.2% agarose gel and were made visible by ethidium bromide staining. PCR product purification and DNA sequencing were conducted through MegaBace high output sequencer (Yaazh Xenomics, Coimbatore, India). The received raw sequences were concised using MEGA 6.0 software (Mega Version 6, Pennsylvania, United States) by analysing electrophorogram peak clarities, and unreliable peaks were not included in the analysis. The amplified 18S rDNA gene sequences were calculated for the percentage of resemblance in the BLAST program on the NCBI website. The higher level of similarity (95–100%) compared to the reference sequence, served as evidence for species identification. All sequences were submitted to Genbank via Bankit, as per NCBI’s procedure. Thraustochytrid rDNA was successfully sequenced and blasted against the complete NCBI Genbank database, which was aligned and analyzed using the CLUSTAL W Multiple Sequence Alignment Program (Thompson et al., 1994). The phylogenetic tree was made using maximum likelihood method along with reference thraustochytrid gene sequences and statistical analysis of 1000 bootstrap replicates was used to assess the species relationship, and the Crypthecodinium cohnii genus was used as the out-group.
Effect of pH, salinity, and temperature tolerance
Thraustochytrid strains were exposed to different stress conditions such as temperature, pH, and salinity (Kalidasan et al., 2021b). The pH tolerance was screened by growing the culture in GPY broth with a pH range of 2-11, by maintaining salinity of 30 g L-1 and temperature at 30°C. Salinity tolerance was studied by growing the culture in GPY broth with a salinity range of 0-100 g L-1 at 5 g L-1 interval by keeping temperature at 30°C and pH of 7.2. Temperature tolerance was screened by growing the culture in GPY broth by keeping in different temperatures in a range of 0-50°C at 5°C interval by maintaining salinity in 30 g L-1 and pH of 7.2.
Biomass production and determination of dry cell weight
The pure cultures of thraustochytrid strains were cultured separately in GPYS production broth medium in a shaken at 180 rpm (Orbitek Shaker, Scigenics Biotech, Chennai, Tamil Nadu, India), pH of 7.2, and kept at 28°C for 2-7 days. In order to prevent contamination, sterile cotton was used to plug each culture flask. The cultures were scaled up by inoculating to a sterile 1 L of modified glucose (12 g L-1), peptone (3 g L-1), monosodium glutamate (1.25 g L-1), yeast (2.5 g L-1), and thiamine (1 g L-1) broth medium in a 5 L flask for biomass production, by keeping pH of 7.2, and temperature at 28°C for 2-7 days.
Thraustochytrid biomass was collected through centrifugation at 10000 × g for 5 min in 50 mL conical bottom centrifuge tube (Hi media, Mumbai, India). The cell pellet was washed thrice with sterile distilled water to take away an unspent medium component from the biomass. The cell pellet samples were then freeze-dried at -49°C, and the amount of biomass was measured as grams of dry weight biomass per litter. The biomass was kept in sealed containers at -80°C for further research.
Total lipid extraction and fatty acid methyl ester analysis
An aliquot of 200 mg of freeze-dried biomass was used for the extraction of total lipid using chloroform-methanol (2:1, v/v) method as described by Folch et al. (1957). The total lipids were transferred to an air-tight vial and allowed to dry, free from solvent using nitrogen gas. The dry lipid was added with 1 ml of 4% methanolic HCl mixed thoroughly, and the mixture was incubated in 80°C in the chromatographic vial for 18 hrs in an oven for trans-esterification reaction (Kashiwagi et al., 1997). The upper organic phase was carefully transferred to a chromatographic vial and evaporated to dryness using nitrogen gas, and then 1 ml of ethyl acetate was added to the content of the vial and analyzed for fatty acid methyl esters (FAME) through GC-MS (Agilent 7890A - 240 MS with Ion Trap). The GC-MS was fitted with a silica capillary column (Agilent J&W, HP-5ms of 30 m x 0.250 mm x 0.25 µm) connected to MSD. The carrier gas used was Helium (1 ml/min) and the mobile phase was Nitrogen (35 ml/min). The oven temperature was programmed with an initial temperature of 140°C at 1 min, then increased at a rate of 2°C/min to achieve the final temperature of 220°C and held for 1 min. The injector temperature was set at 260°C and kept sample volume of 1μl and split ratio of 100:1. An external standard mix (FAME Mix C4 - C24, Sigma Aldrich, Burlington, MA, USA) was used to standardize the composition of FAME. The MS acquisition method was set with solvent delay of 5 min, maintaining trap temperature of 176°C, manifold temperature of 70°C, transfer line temperature of 270°C and ion source temperature of 205°C. The individual constituents shown by GC and their relative concentrations were identified by comparing their standard compounds of NIST and Willey libraries.
Carotenoid analysis
Thraustochytrids (Thraustochytrium sp., and A. mangrovei) were cultured in culture media at optimal conditions of 20°C for 12 hours interval of light source. Their biomass was separated by centrifugation at 8000 × g for 10 min in a 50 mL conical bottom centrifuge tube (Himedia, Mumbai, India) and washed the biomass two times with sterile double distilled water to remove media components. After that, the cells were freeze-dried (−49°C) and weighed. Biomass was kept at −80°C in sealed containers for further analysis. Carotenoid extraction was done with dimethyl sulfoxide and then extracted with acetone. Samples were analyzed for pigments using the method described by Pawar et al. (2021). Extracted carotenoid pigments were stored at −49°C in a light protected environment and analyzed using high-performance liquid chromatography (HPLC) (Nova-Pak silica, 60 Å, 4-m, 150 mm long × 2.1 mm diameter, Waters Inc, Milford, Massachusetts, USA). To quantify each pigment, commercial -carotene, canthaxanthin, and astaxanthin (Sigma-Aldrich, Burlington, MA, United States) were used as standards.
Preparation and extraction of secondary metabolites using solvent extraction
The 1000 mg of freeze-dried biomass was extracted for intracellular metabolites in 5 ml of n-butanol, chloroform, methanol, and petroleum ether, separately. The extracts were centrifuged at 8000 × g for 12 min, and the supernatant was collected and dried in a rotary vacuum evaporator at 40°C for in-vitro antimicrobial activity (Kalidasan et al., 2015a).
In vitro antibacterial activity
The antibacterial efficacy of A. mangrovei and Thraustochytrium sp., was tested against human clinical bacterial pathogens such as Klebsiella pneumonia, Bacillus subtilis, Salmonella typhi, Escherichia coli, Staphylococcus aureus, Proteus mirabilis and Vibrio cholera, obtained from Pathology Department, Rajah Muthaiah Medical College, Annamalai University, Chidambaram, Tamil Nadu, India.
The antibacterial activities were evaluated by agar disc diffusion method (Kalidasan et al., 2014; Kalidasan et al., 2015a). A 100 μl of fresh bacterial culture was inoculated into nutrient broth and incubated at 37°C for 24 h. For each bacterial strain, 100 μl of a 24 h old culture of cell suspension was poured onto the nutrient agar plates and spread thinly to entire nutrient agar with a glass spreader aseptically. The 100 μl of A. mangrovei and Thraustochytrium sp. extracts were poured separately and with standard ampicillin antibiotic on to the sterile disc with 6 mm diameter (Himedia, Mumbai, India) and kept for 30 min at 30°C for solvent evaporation, and then the discs were impregnated on to the nutrient agar plates aseptically. Following that, the discs were then implanted on inoculated culture plates, which were incubated at 37°C for 24 h. Antimicrobial activity was calculated as diameter of zone of inhibition, without the paper disc diameter. All experiments were carried out in triplicates.
Minimum inhibitory concentration
Based on the antibacterial activities, only petroleum ether was found to be sensitive to Thraustochytrium sp. and n-butanol extract was found to be sensitive to A. mangrovei; hence, the solvent extracts were chosen for the minimum inhibitory concentration (MIC) assay. The MIC of extract was determined against clinical pathogens using the method of Seedevi et al. (2013). One mg mL-1 stock solution was prepared and serially diluted to different concentrations of 25, 50, 75, and 100 μg mL-1 and standard ampicillin in 1 mg mL-1 (Himedia, Mumbai, India). A test tube with 50 µl of each of the dilutions containing 2.0 ml of nutrient broth was obtained and inoculated with 0.5 ml of old bacterial culture. The control test tube was maintained only with culture broth medium and bacterial cells. The control and sample test tubes were maintained at 37°C for over-night. The MIC of a compound was determined by selecting the extract tube with the lowest concentration that failed to exhibit any observable evidence of growth following the incubation period.
Antioxidant assays and estimation
An aliquot of 2 ml methanol was used to extract the 100 mg freeze-dried biomass. The samples were incubated for 60 min at 150 rpm, in 28°C, and then centrifuged at 5000 × g for 10 min. After three extractions, all supernatants were combined, and the extracts were concentrated under vacuum in a rotary evaporator at 40°C. Then the extract was prepared in five different concentrations (50, 100, 150, 200, and 250 μg mL-1) and evaluated for antioxidant activities using six different assays, such as Total phenol content (Singleton et al., 1999), Hydrogen peroxide radical inhibition assay (Govindarajan et al., 2003), DPPH radical scavenging assay (Narwal et al., 2014), Total antioxidant activity (Yu et al., 2017), Reducing power (Venuste et al., 2013), and Nitric oxide radical scavenging assay (Govindarajan et al., 2003). The antioxidant properties are expressed in percentage of the L-ascorbic acid. Each experiment was done in triplicates.
Statistical analysis
The IBM-SPSS (version-16) statistical software was used for the data analysis. All in vitro results were analyzed using one-way ANOVA and calculated as mean ± SD. The p values less than 0.05 indicates statistical significance between mean values.
Results and discussion
Isolation and identification of thraustochytrids
A total of 36 thraustochytrid strains was isolated from MSL using direct plating method. After 48 h of incubation the thraustochytrids were observed in white, pale white, oily, orange colour with smooth, rough surface and/or uneven surface. They were sub-cultured aseptically to fresh culture medium, and only eight strains survived after 3 times of sub-culturing once in 2-7 days. The two predominant strains were identified as Thraustochytrium sp., and Aurantiochytrium mangrovei, based on their morphological characters such as colour, shape, size, formation of ecto-plasmic network, cluster formation, presence of vegetative cells, binary division, zoospore formation, and amoeboid cell production, when visualized under the light and scanning electron microscopes (Figures 2A, B) following the keys of Honda et al. (1999); Leander and Porter (2001), and Marchan et al. (2018). The vegetative cells of Thraustochytrium sp., appeared round in shape with a diameter range of 7.3-16.8 µm and that of A. mangrovei looked spherical in shape with a diameter range of 6.2-20.38 µm. The cytoplasmic content of the cells in Thraustochytrium sp., acted as sporangia to develop many amoeboid cells after settlement and then released motile zoospores. The vegetative cell in A. mangrovei was biparted sequentially, resulting in a cluster of cells. The ectoplasmic net was not well–developed and proliferation body was delineated during zoospore formation.
Figure 2
(A a) Morphological, (b) light and (c) scanning electron microscopic images of Thraustochytrium sp., (B a) Morphological, (b) light and (c) scanning electron microscopic images of Aurantiochytrium mangrovei.
Thraustrochytrids are known to grow on the surface of decaying mangrove leaves (Kalidasan et al., 2019). Similar to the present work, a few reports are available. A previous study has isolated 11 strains of thraustochytrids from mangrove habitats of Kerala, India, with the most predominance of A. mangrovei (Jaseera et al., 2018). Similarly, 12 thraustochytrids strains are isolated from the decomposing mangrove leaves of Andaman Islands and they are grouped under two genera (Thraustochytrium and Aurantiochytrium). Both genera were reported for the first time in the mangrove habitats of the Andaman Islands, and Aurantiochytrium sp. was the most abundant species with ubiquitous distribution in most of the sampling stations (Kalidasan et al., 2021b). In another study, Thraustochytrium sp., is isolated from decomposing mangrove leaves of South India using a serial dilution and pollen baiting (Kabilan et al., 2018). Further, the present work analysed molecular phylogenetic relationship, confirmed by 18S rDNA region from mangrove-derived thraustochytrid isolates and employed the final alignment by NCBI blast analysis. This revealed that the mangrove-derived thraustochytrid strain, Thraustochytrium sp., (Accession No. KT716335) was found closer by 100% similar to Thraustochytrium sp. S7 (KF683340), 93.91% with Thraustochytrium (KT598545), 93.43% with Thraustochytrium sp. Yonez6-8 (AB810969). Whereas A. mangrovei (Accession No. KT716337) was found closer by 100% with A. mangrovei Sk02 (JF260953), 98.17% with A. mangrovei BT3 (OP175985), 98% with Aurantiochytrium sp. MBT02A (MH595608) (Figure 3). The phylogenetic analyses confirmed the taxonomic position of the thraustochytrid species from 93.43% to 100%. Two strains with full-length 18S sequence identities of less than 92% might be categorized as to belong a separate genera, whereas the identities of 92% to 97% were congeneric species, and the identities of more than 97% validated the species level identification (Dellero et al., 2018). Further work is required on thraustochytrids taxonomy on redefining clear taxonomic features based on whole genome sequences to establish the identification at species level.
Figure 3

Maximum likelihood method phylogenetic tree analysis of thraustochytrid isolates (TSKK5 and TSKK7) using 18S rDNA and Crypthecodinium cohnii genus was used as the out-group.
Stress tolerance
Thraustochytrium sp. and A. mangrovei were tested for growth at various levels of salinity, temperature, and pH (Table 1; Supplementary Table 1). Both the thraustochytrids showed fair growth at pH of 5.5 and 8.5, moderate growth at pH 6 and 8, and they grew well in the pH range of 6.5 - 7.5. Both the species exhibited positive growth at pH range of 5.5 and 9; however, negative growth was observed at pH of 3 - 5, and 9.5 - 12. This study confirmed the neutral pH as ideal for growth of thraustochytrids (Table 1) in accordance with earlier reports (Jaseera et al., 2018, Kalidasan et al., 2021b). Thraustochytrids are also reported to grow and produce high biomass in alkaline pH environments, and any reduction in pH harshly affects the growth and biomass production (Taoka et al., 2009).
Table 1
| Isolates | Growth range of temperature tolerances | Optimum temperature | Growth range of pH tolerances | Optimum pH | Growth range of salinity tolerances | Optimum salinity | Astaxanthin (µg.L-1) |
|---|---|---|---|---|---|---|---|
| TSKK-05 | 10–35 | 25–30 | 5–8.5 | 6.5–7.5 | 0–100 | 25–30 | - |
| TSKK-07 | 10–35 | 25–30 | 5–8 | 6.5–7.5 | 0–100 | 25–30 | 3.2 |
Screening of physical parameters tolerance ranges for optimal culture conditions and Astaxanthin production.
Temperature influenced the growth of thraustochytrids. Thraustochytrium sp., and A. mangrovei displayed growth from 10°C to 35°C with an optimal range of 25-30°C. Thraustochytrium sp., exhibited no growth at 5°C and 10°C, whereas A. mangrovei showed moderate growth at 10°C and 15°C. Both the strains did not show any growth at 5°C, 40°C, 45°C and 50°C (Table 1). Remarkably, the colour of A. mangrovei culture changed at 15°C and 20°C revealing the pigment production. Temperature also plays a crucial role in the production of biomass and DHA in thraustochytrids. High temperature is associated with high biomass production (Leano et al., 2003), whereas low temperature is associated with high DHA production (Caamano et al., 2017). The current study recorded the maximum temperature tolerance up to 35°C, which is consistent with earlier workers (Jaseera et al., 2018). However, thraustochytrids are known to grow and survive in the temperature range of 10-35°C in culture conditions in accordance with the temperature of habitat from where the strains have been isolated (Kalidasan et al., 2021b).
Thraustochytrids grew well at salinities ranging from 25 to 35 g L-1. A. mangrovei grew moderately at 15 to 20, and 40 to 45 g L-1, fairly at 10 to 15, and 50 - 60 g L-1, and negatively at 0 and 65 to 100 g L-1. Thraustochytrium sp., on the other hand, grew moderately at 20, 40 to 50 g L-1, fairly at 5 - 15 and 60 - 70 g L-1, and negatively at 0 and 75 to 100 g L-1. Thraustochytrids are known to grow in a wide range of salinities (0 - 100 g L-1), but grow the best at 20 - 30 g L-1, and the salinity plays a significant role in lipid accumulation (Kalidasan et al., 2021b), and this is in accordance with the present result (Table 1). Interestingly, thraustochytrid strains were recorded to grow in lower salinity, but both biomass and lipid yield were significantly decreased, lending support to earlier works on Thraustochytrium (Kalidasan et al., 2021b), Aurantiochytrium (Jaseera et al., 2018), and on Schizochytrium (Kamlangdee and Fan, 2003). In general, the microbes isolated from estuarine and mangrove habitats exhibit salinity tolerance due to the fluctuating salinity levels in their native habitats (Kalidasan et al., 2021b), which is similar to the current work.
Biomass production
Thraustochytrids were cultured at the optimal conditions of 28 g L-1 salinity, 7.2 pH, 28°C temperature, 12 g L-1 of glucose, 3 g L-1 of peptone, 1.25 g L-1 of monosodium glutamate, 2.5 g L-1 of yeast, and 1 g L-1 of thiamine, under 150 × g agitation for 4 days of incubation. The maximum amount of biomass produced by A. mangrovei was 6.25 g L-1 and by Thraustochytrium sp., was 4.72 g L-1 (Figure 4A). These results are in consistent with those of Russo et al. (2021), where A. mangrovei strain RCC893 shows its highest growth at 28°C. The thraustochytrids are reported to require carbon and nitrogen sources for biomass production, lipid and DHA accumulation (Chang et al., 2014; Sahin et al., 2018), in addition to culture conditions, such as nutrients (0.8 - 48 g L-1), temperature (25 - 28°C), pH (4 - 9), and incubation time (4 - 12 days) (Yaguchi et al., 1997; Jaseera et al., 2018).
Figure 4

(A) Biomass, (B) total lipid, and major omega-3 fatty acid production of the Pichavaram thraustochytrids isolates.
The biomass production varied with thraustochytrid species. The biomass production was higher in A. mangrovei than that in Thraustochytrium sp. In general, Schizochytrium is reportedly producing higher biomass than Thraustochytrium. For instance, Schizochytrium aggregatum produces 0.9 g L-1 biomass (Vazhappilly and Chen, 1998), while, Aurantiochytrium sp., produces 7 - 11 g L-1, after 10 days of growth (Jaseera et al., 2018). Carbon is a key regulatory component for production of biomass, lipids, and fatty acids (Mariam et al., 2021; Pawar et al., 2021). Glucose was chosen as the carbon source for the present work based on the earlier workers (Abad and Turon, 2015). Nitrogen is also important nutrient source for growth, development, and lipid and DHA production in thraustochytrids (Marchan et al., 2018; Pawar et al., 2021). The present study used yeast extract and peptone as suitable nitrogen sources to boost biomass and total fatty acids production, based on the earlier report (Heggeset et al., 2019).
The A. limacinum SR21 is recorded to produce the biomass of 3.4 ± 0.4 g L-1, under fed-batch culture, while the same strain under optimized culture conditions is found to yield high biomass of 14.3 ± 0.5 g L-1 dry weight after 7 days of incubation (Aini et al., 2022). Hence, the optimization of culture conditions, and nutrient sources produce the maximum biomass of thraustochytrids.
Lipid and fatty acids profiles
The fatty acid profile of thraustochytrids was analyzed using GC-MS, and their peaks were identified and quantified using the NIST Version-Year 2005 MS Library (Table 2; Supplementary Figures 1, 2). The total lipid (TL) was 42.36% in Thraustochytrium sp., and 49.81% in A. mangrovei. The percentage of major omega-3 PUFAs varied with the species. For example, eicosapendaenioc acid (EPA C20:5) was 7.92% in Thraustochytrium sp., and 5.08% in A. mangrovei, while docosapentaenoic acid (DPA C22:5) was 3.16% in Thraustochytrium sp., and 5.89% in A. mangrovei (Figure 4B). The docosahexaenoic acid (DHA C22:6) was 32.69% in Thraustochytrium sp., and 44.71% in A. mangrovei (Table 2). Palmitic acid (16:0) was the most abundant saturated fatty acid in A. mangrovei, accounting for 28.23% of total fatty acids, while it was 31.76% in Thraustochytrium sp. In general, high content of palmitic acid and DHA was recorded in both the species. Both the species had a similar profile of fatty acids, composed of mainly of 14:0, 16:0, 20:5, 22:5 and 22:6, contributed to maximum percentage of total fatty acids.
Table 2
| Carbon atoms | Name of the fatty acids | Thraustochytrium sp. | A. mangrovei |
|---|---|---|---|
| C4:0 | Butanoic acid, methyl ester | 0 | 0.02 |
| C7:0 | Heptanoic acid, methyl ester | 0.14 | 0 |
| C11:0 | cis-10-undecanoic acid, methyl ester | 0.12 | 0.29 |
| C12:0 | cis-10-dodecanoic acid, methyl ester | 0.64 | 0.02 |
| C13: | cis-12-tridecanoic acid, methyl ester | 4.09 | 0.43 |
| C14: | Tetradecanoic acid, methyl ester | 2.23 | 7.58 |
| C14:1 | cis-13-Tetradecanoic acid, methyl ester | 0.26 | 0.03 |
| C15: | Pentadecanoic acid, methyl ester | 0.34 | 1.11 |
| C16: | Hexadecanoic acid, methyl ester | 31.76 | 28.23 |
| C16:1 | 9-Hexadecenoic acid, methyl ester | 0.82 | 0.15 |
| C16:2 | cis-9,12-hexadecadienoic acid, methyl ester | 0.43 | 0.07 |
| C16:3 | cis-7,10,13-Hexadecatrienoic acid, methyl ester | 0 | 0.05 |
| C17:1 | cis-16-heptadecanoic acid, methyl ester | 3.29 | 0.56 |
| C17:3 | cis-8,11,14-heptadecatrienoic acid, methyl ester | 0.38 | 0.11 |
| C18: | Octadecanoic acid, methy ester | 3.61 | 2.56 |
| C18:1 | cis-13-octadecenoic acid, methy ester | 0.05 | 0.14 |
| C18:2 | cis-5,12-octadecadienoic acid, methyl ester | 0.03 | 1.08 |
| C18:3 | cis-9,12,15-Octadecatrienoic acid, methyl ester | 0.13 | 0 |
| C20: | Eicosanoic acid, methyl ester | 5.64 | 0.27 |
| C20:3 | Methyl 7,11,14-eicosatrienoic acid, methyl ester | 0.33 | 0.34 |
| C20:4 | cis-8,11,14,17-eicosatetraenoic acid, methyl ester | 1.94 | 0.87 |
| C20:5 | cis- 5,8,11,14,17-eicosapentaenoic acid, methyl ester | 7.92 | 5.08 |
| C21:5 | cis-20-heneicosanoic acid, methyl ester | 0 | 0.08 |
| C22:5 | cis-7,10,13,16,19-docosapentaenoic acid, methyl ester | 3.16 | 5.89 |
| C22:6 | cis-4,7,10,13,16,19-Docosahexaenoic acid, methyl ester | 32.69 | 44.71 |
| C24:6 | cis-1,6,10,14,18,22-Tetracosahexaenoic acid, methyl ester | 0 | 0.33 |
Fatty acid composition (expressed as % of the total fatty acids) of Thraustochytrium sp., and Aurantiochytrium mangrovei.
In general, the lipid and DHA productions vary with microbial strains, culture conditions, and nutrients used in the culture media. The fatty acid composition of thraustochytrids is known to be altered by carbon and nitrogen sources (Laddha et al., 2021). In thraustochytrid strain G13, a high content of carbon and nitrogen is reported to increase accumulation of lipids and DHA (Bowles et al., 1999). An Indian strain of A. mangrovei accumulates DHA as high as 22 - 60% of total fatty acids (Jaseera et al., 2018). The thraustochytrids have gained prominence as a source of PUFA-rich biomass and oils (Raghukumar, 2008), and hence they are used to enrich PUFA in live foods for fish larvae (Sprague et al., 2015). Moreover, there are no reports about toxic chemicals and diseases produced by the thraustochytrids (Kalidasan et al., 2015b). DHA and EPA have utility values in enhancing neural development (Ratledge, 2004), lowering hypertension (Boyer-Diaz et al., 2020), anti-cardiovascular (Liao et al., 2022), and in anticancer properties (Kalidasan et al., 2022). Currently, fish and fish oils are the primary sources of DHA. However, the DHA content of fish oil is low, and large-scale production of DHA from fish oil is difficult (Kalidasan et al., 2021b). Overfishing of fish stocks and global warming are known to decline in fish populations, causing a disruption in the DHA demand, and supply flow chain (Liang et al., 2022). In this connection, thraustochytrids have the greatest potential for fish oil replacement because they contain more DHA and EPA than fish oil (Song et al., 2015). Biomass of thraustochytrids has 10–50% total oil; of which, 30–70% is DHA (Ward and Sing, 2005). The fatty acid profiles of thraustochytrids are stable, renewable, safer and these factors make them as a suitable source for the production of DHA with a wide range of commercial applications in the pharmaceutical and nutraceutical industries (Paliwal et al., 2019; Mariam et al., 2021). In the present study, Thraustochytrium sp., and A. mangrovei were found to accumulate DHA of 32.69% and 44.71% respectively (Figure 4). There is a growing market demand for omega-3 PUFA, which was 4.3 billion USD in 2019 (Aasen et al., 2016). An extensive research is required to optimize the culture growth conditions of thraustochytrids for commercial production of PUFA.
Astaxanthin production
Carotenoids are commercially important, fat-soluble, natural food colorants with health benefits such as embryonal development, visual function, cellular signalling, and antioxidant activity (Stahl and Sies, 2005; Leyton et al., 2021). Thraustochytrids are capable of producing a variety of pigments, but mainly astaxanthin and β-carotene. This is due to simultaneous synthesis of carotenoid pigments and oxidation of omega-3 fatty acids. The amount and composition of carotenoids depend on the species and their growth media temperature and composition. Although the role of carotenoids in photosynthetic organisms is well known, their function in non-photosynthetic organisms such as thraustochytrids is unclear. In extreme and fluctuating physico-chemical conditions, the antioxidative capacity of carotenoids may contribute to protect the microbial cells against environmental stresses. The thraustochytrids isolated from Pichavaram mangroves were recorded to accumulate carotenoids by the change of culture medium to light orange and orange after 4 – 5 days of incubation at 20°C (Figure 5). Lower temperature and LED light exposure are also reported to positively influence carotenoid production in Schizochytrium sp. (Park et al., 2018). Astaxanthin production is negatively influenced in the culture flask at 30°C confirmed that temperature plays important role in astaxanthin production (Pawar et al., 2021). The carotenoid production is high in mutant strain of Aurantiochytrium sp. (Watanabe et al., 2018). The astaxanthin production in thraustochytrids is mainly affected by light supply, oxygen level, nutrient composition, and various stress factors (Park et al., 2018). The present work recorded astaxanthin production of 3.2 µg L-1, whereas β-carotene was at undetectable level in A. mangrovei (Supplementary Figure 3), and this can be attributed to the conversion efficiency of beta-carotene to astaxanthin in the carotenoid pathway, as well as genetic and culture-related factors (Kumari et al., 2020; Rathod et al., 2020).
Figure 5

Astaxanthin production by A mangrovei (TSKK7) at 20°C (A) Initial period of 24 h, (B) after 72 h, (C) 120 h.
Antibacterial activity
Thraustochytrids are present in mangrove leaf litter, along with other saprophytic microbes (Kalidasan et al., 2019). In order to compete with other microbes for survival and multiplication, the thraustochytrids have to produce antimicrobial substances (Kalidasan et al., 2015a). However, only a few reports are available on the antimicrobial activity of thraustochytrids (Vu et al., 2022). The n-butonol extract of mangrove-derived thraustochytrids is reported to show the highest antibacterial activity in terms of inhibition zone (21.66 ± 1.52 mm) against Staphylococcus aureus (Kalidasan et al., 2015a). The extracellular polymeric substances of Thraustochytrium striatum are found to have antibacterial activity against gram-positive and gram-negative bacterial species with the maximum zone of inhibition (30 mm) against P. aeruginosa (Xiao et al., 2018). This inhibitory activity is attributed to the destruction of bacterial cell walls caused by hydrolytic enzymes of thraustochytrid-origin (Kathiresan et al., 2011). The fatty acids and their derivatives extracted from thraustochytrids are proved to have antibacterial (Vu et al., 2022), antioxidant (Kalidasan et al., 2015b), antiviral (Ramos-Vega et al., 2018), and anticancer properties (Kalidasan et al., 2022).
In the present work, the freeze-dried Thraustochytrium sp. and A. mangrovei extracted in n-Butanol, Chloroform, Methanol and Petroleum ether exhibited a wide spectrum of antibacterial activity against seven clinical pathogens. The zone of inhibition by Thraustochytrium sp., was recorded to be the highest (17.33 ± 2.08 mm) against S. aureus (Figure 6A), and the lowest (4.61 ± 0.57 mm) against K. pneumonia. Similarly, the zone of inhibition by A. mangrovei extract was recorded to be the maximum (14.75 ± 2.08 mm) against S. typhi (Figure 6B), and the minimum (5.78 ± 2.00 mm) against B. subtilis. As a positive control, ampicillin showed the activity against S. aureus (22 ± 2.00 mm) and the least activity against B. subtilis (15 ± 1.52 mm) (Table 3).
Figure 6

(A, B) Invitro antibacterial activity of mangrove-derived strain Thraustochytrium sp., and A. mangrovei against S. aureus and S. typhi.
Table 3
| Clinical Pathogen | Zone of Inhibition (mm) (Mean ± S.D) | Ampicillin | |||||||
|---|---|---|---|---|---|---|---|---|---|
| n-Butanol | Methanol | Petroleum ether | Chloroform | ||||||
| T | A | T | A | T | A | T | A | ||
| E. coli | 7.60 ± 1.15 | 9.55 ± 1.52 | 7.82 ± 1.52 | 6.33 ± 1.52 | 4.65 ± 0.57 | 9.40 ± 1.15 | 13.33 ± 1.52 | 9.53 ± 1.52 | 18 ± 2.08 |
| K.pneumonia | 7.33 ± 1.52 | 5.10 ± 0.57 | 4.61 ± 0.57 | 9.24 ± 1.52 | 13.16 ± 1.00 | 11.20 ± 1.52 | 13.30 ± 1.52 | 6.76 ± 1.52 | 16 ± 1.52 |
| P. mirabilis | 13.00 ± 2.00 | 7.33 ± 1.52 | 10.60 ± 2.0 | 8.00 ± 1.00 | 8.56 ± 0.57 | 6.79 ± 1.52 | 12.70 ± 1.52 | 9.32 ± 1.52 | 17 ± 1.15 |
| S. typhi | 11.64 ± 1.15 | 14.75 ± 2.08 | 11.45 ± 2.0 | 7.30 ± 2.08 | 7.30 ± 0.57 | 12.87 ± 2.51 | 5.44 ± 0.57 | 14.05 ± 2.00 | 20 ± 1.73 |
| S. aureus | 9.00 ± 1.00 | 8.32 ± 1.52 | 9.63 ± 1.52 | 9.25 ± 1.52 | 17.33 ± 2.08 | 13.00 ± 2.00 | 8.35 ± 1.52 | 7.00 ± 1.73 | 22 ± 2.00 |
| V. cholera | 15.30 ± 1.5 | 9.47 ± 1.52 | 8.66 ± 1.15 | 6.60 ± 1.15 | 9.65 ± 1.52 | 11.00 ± 1.73 | 11.34 ± 0.57 | 9.32 ± 1.15 | 19 ± 1.00 |
| B. subtilis | 9.00 ± 2.00 | 12.66 ± 2.0 | 7.38 ± 1.52 | 5.78 ± 2.00 | 5.18 ± 1.15 | 6.34 ± 1.52 | 12.23 ± 1.15 | 7.15 ± 0.57 | 15 ± 1.52 |
Antibacterial activity of Thraustochytrium sp., and Aurantiochytrium mangrovei extracts, against clinical human pathogens.
T- Indicates Thraustochytrium sp., A- indicates Aurantiochytrium mangrovei.
Petroleum ether extract exhibited the maximum antibacterial activity (17.33 ± 2.08 mm) against S. aureus (Table 3) similar to an earlier work tested against five human and four fish bacterial pathogens (Kalidasan et al., 2021b). This activity can be attributed to the PUFAs present in thraustochytrids (Kalidasan et al., 2015a ; Kalidasan et al., 2021b). Fatty acids, especially DHA and EPA have bactericidal activity against pathogenic microbes of S. aureus, B. subtilis, and Pseudomonas aeruginosa (Shin et al., 2007; Desbois and Lawlor, 2013). Thus, thraustochytrids are to be considered as a promising source of antimicrobials in controlling clinical pathogens, after undertaking purification and characterization of active lead molecules.
The petroleum ether extract from Thraustochytrium sp., was found to have a MIC of 100 μg mL-1 against human clinical bacterial strains such as E. coli, P. mirabilis, S. typhi, V. cholera, and B. subtilis, while the MIC was 60 μg mL-1 against K. pneumonia and 40 μg mL-1 against S. aureus. The MIC of n- butanol extract from A. mangrovei was determined to be 100 μg mL-1 for E. coli, K. pneumonia, P. mirabilis, S. aureus, V. cholera, while the MIC was 80 μg mL-1 against B. subtilis and 60 μg mL-1 against S. typhi (Table 4). This is in accordance with an earlier work of Vu et al. (2022) who have reported the MIC value of 128, 256, and 32 μg mL-1 against E. faecalis, S. aureus, and B. cereus respectively in the crude extract of Schizochytrium limacinum. However, extracellular polymeric substances of T. striatum do not exhibit the MIC up to 10 mg mL-1 against P. aeruginosa (Xiao et al., 2018).
Table 4
| HCP | Name of the Solvent | Name of the Strains | 20 μg/ml | 40 μg/ml | 60 μg/ml | 80 μg/ml | 100 μg/ml | +ve (C) | -ve (C) |
|---|---|---|---|---|---|---|---|---|---|
| E. coli | Petroleum ether | TS | +++ | – | +++ | ||||
| n-Butanol | AM | +++ | +++ | ++ | + | * | - | +++ | |
| K. pneumonia | Petroleum ether | TS | ++ | + | * | – | – | – | +++ |
| n-Butanol | AM | +++ | +++ | +++ | ++ | + | - | +++ | |
| P. mirabilis | Petroleum ether | TS | +++ | +++ | ++ | + | * | – | +++ |
| n-Butanol | AM | +++ | +++ | ++ | + | * | - | +++ | |
| S. typhi | Petroleum ether | TS | +++ | +++ | ++ | + | * | – | +++ |
| n-Butanol | AM | ++ | + | * | - | - | - | +++ | |
| S. aureus | Petroleum ether | TS | + | * | – | – | – | – | +++ |
| n-Butanol | AM | +++ | +++ | ++ | + | * | - | +++ | |
| V. cholera | Petroleum ether | TS | +++ | +++ | ++ | + | * | – | +++ |
| n-Butanol | AM | +++ | +++ | ++ | + | * | - | +++ | |
| B. subtilis | Petroleum ether | TS | +++ | +++ | +++ | ++ | + | – | +++ |
| n-Butanol | AM | +++ | ++ | + | * | - | - | +++ |
Minimum Inhibitory Concentrations (MIC) of Thraustochytrium sp., and Aurantiochytrium mangrovei extracts, against clinical human pathogens.
HCP, Human clinical pathogens; TS, Thraustochytrium sp.; AM, Aurantiochytrium mangrovei; +++ Indicates highly turbid, ++ Indicates turbid solution, + Indicates cloudy solution, * Indicates considerably arrest, - No growth, C – Control.
Antioxidant activity
Total antioxidant activity was 83.79 ± 1.10% in methanol extract of Thraustochytrium sp., and 80.92 ± 2.10% in A. mangrovei in comparison with standard L-ascorbic acid (Figure 7A). The methanolic extract exhibited nitric oxide radical content of 75.22 ± 2.09% and 72.88 ± 1.63% in Thraustochytrium sp., and A. mangrovei respectively at 500 μg mL-1, but at 25 μg mL-1 it was lower (30.16 ± 1.02% and 31.04 ± 1.70%) (Figure 7B). Thraustochytrids impeded nitrite initiation by competing directly with oxygen in the reaction with nitric oxide. The methanolic fraction had the highest hydrogen peroxide radical scavenging activity of 80.28 ± 1.75% for Thraustochytrium sp., and 79.24 ± 1.58% for A. mangrovei at high concentration of the extract (Figure 7C).
Figure 7

(A) Total antioxidant (%) activity (B) Nitric oxide radical inhibition (%) (C) Hydrogen peroxide radical inhibition (%) (D) DPPH free-radicals scavenging (%) and (E) Total phenol (%) and (F) Total reducing power (%) in extracts of Thraustochytrium sp., and A mangrovei at different concentrations.
The DPPH-free radical scavenging activity was 88.24 ± 1.64% in A. mangrovei, and 86.74 ± 1.50% in Thraustochytrium sp. (Figure 7D). Total phenol content in A. mangrovei was 84.79 ± 1.65% while it was 83.45 ± 1.37% in Thraustochytrium sp., at 500 μg mL-1, but at 25 μg mL-1, the total phenol content was low in Thraustochytrium sp. (36.43 ± 0.62%) and A. mangrovei (37.11 ± 1.76%) (Figure 7E). Total reducing power activity was 76.36 ± 0.98% in Thraustochytrium sp., and 75.16 ± 1.32% in A. mangrovei at 500 μg mL-1, but the activity was lower at 25 μg mL-1 (Figure 7F).
The thraustochytrids are a rich source of natural antioxidants (Duan et al., 2006). The present work also found increased antioxidant activity with increasing concentrations of thraustochytrid extracts, which is in consistent with previous reports (Kalidasan et al., 2015b; Yu et al., 2017). The extracellular polymeric substances of Thraustochytrium striatum are shown to have promising total antioxidant capacity at 100 μg mL-1 (Xiao et al., 2018). The extract of Schizochytrium sp., is reported to have the highest total antioxidant activity of 87.37± 1.22% (Kalidasan et al., 2022). The reducing capability of a compound is used to predict its antioxidant activity (Meir et al., 1995). The electron donor and free radical passivation potential depends on reducing ability of the compound (Singh and Rajini, 2004). Reducing agents inhibit lipid peroxidation by donating a hydrogen atom, halting the chain reaction that causes membrane lipid damage (Xing et al., 2005). Natural polyphenolic compounds are the groups of metabolites which play a significant role in natural remedies through the scavenging of radicals which tend to increase with polyphenol concentration. Total phenol content and antioxidant activity have a strong relationship (Kim et al., 2002). Phenolics are the major components in Schizochytrium sp., contributing to antioxidant activity, and promising for application in health products or cosmetics (Yu et al., 2017).
The most precise antioxidant method is DPPH free radical scavenging assay. The current study found a significant DPPH radical scavenging activity of 88.24 ± 2.36% in A. mangrovei, and 86.74 ± 1.29% in Thraustochytrium sp. A similar observation is reported in thraustochytrids with the highest antioxidant activity of 78.95% (Kalidasan et al., 2015b). The PUFA extract of Aurantiochytrium sp. SC145 is shown to have DPPH activity with a potential therapeutic target for the treatment of neurodegenerative disorders (Hien et al., 2022). The silver and gold nanoparticles synthesized from Thraustochytrium kinnei are found to have potential antioxidant properties (Kalidasan et al., 2021a).
Similar to the present work, the free radical scavenging activity of ethyl acetate extract of S. variabilis is shown to have increased activity of 43.67%-82.86% with increasing concentrations from 0.05 to 5.0 mg mL-1 (Dholakiya et al., 2017). The antioxidant activity is also known to be increased from 7.2 to 11.7 μmol TE g-1 in methanol extract of Schizochytrium sp., when the flax seeds are supplemented at 0.05% and 0.1% to the cultures. Thus, the inclusion of essential fatty acids with improved levels of DHA enhances the anti-oxidation by improving the nutritional value of thraustochytrids (Gaffney et al., 2014). The omega-3 fatty acids are proved to have several pharmacological activities with antibacterial, antioxidant, anti-aging, and anti-cancer properties (Schmitz and Ecker, 2008; Huang and Ebersole, 2010; Guedes et al., 2011; Mozaffarian and Wu, 2011). The abundance of omega-3 fatty acids in thraustochytrids was perhaps responsible for antioxidant and free-radical scavenging activity, leading to high antioxidant activity in the present study. In addition, natural polyphenols are chief groups of metabolites that play an important role in natural medicine in radical scavenging activity that increases with polyphenol concentration (Kim et al., 2002).
Thraustochytrids display a high free radical scavenging activity (Kalidasan et al., 2015b). The antioxidant mediated mechanism of thraustochytrids relates to oxidative stress defense in several human diseases, contributing to increased enzyme activity and decreased lipid peroxides as antioxidant characteristics. Dietary antioxidants can prevent or delay the beginning or propagation of oxidative chain reactions by scavenging free radicals, which delay the oxidation of lipids. Some of the constituents in crude extracts may have additive or synergistic positive effects that increase the anti-oxidative property, whilst other constituents may neutralize or impede the antioxidation (Kulkarni, 1997). The present study proved that mangrove-derived A. mangrovei and Thraustochytrium sp., are a rich source of organic antioxidants. Further purification of the crude extracts of thraustochytrids is required to obtain biologically active metabolites.
Conclusion
The PUFA-rich marine thraustochytrids were isolated from decomposing leaves of mangroves, and identified as Thraustochytrium sp., and Aurantiochytrium mangrovei based on their morphological and molecular characteristics. The production of biomass, total lipids, and PUFA in the thraustochytrids was further investigated. Among two thraustochytrids, A. mangrovei produced the highest biomass of 6.25 g L-1 and contained 49.81% of total lipid and 44.71% of DHA. Astaxanthin pigment accumulated up to 3.2 µg L-1 in A. mangrovei, whereas the pigment was not detected in Thraustochytrium sp. The crude extract of Thraustochytrium sp., and A. mangrovei was evaluated for antimicrobial and antioxidant properties. The petroleum ether extract of Thraustochytrium sp., exhibited a promising antibacterial activity (17.33 ± 2.08 mm) with MIC of 40 μg mL-1 against S. aureus, whereas A. mangrovei showed the highest free radical scavenging activity (87.37 ± 1.22%). The thraustochytrids can further be explored for their utility in the production of Omega-3 fatty acids, pigments, and bioactive compounds of antimicrobial and antioxidant properties.
Supplementary Materials: The Supplementary Materials for this article can be available online at https://www.frontiersin.org/articles/xxx/fmars./S1, Figure S1. GC-MS analysis of FAME from Aurantiochytrium mangrovei for fatty acid composition expressed as % of the total fatty acid, Figure S2. GC-MS analysis of FAME from Thraustochytrium sp., for fatty acid composition expressed as % of the total fatty acid, Figure S3. HPLC chromatogram of astaxanthin pigment in Aurantiochytrium mangrovei and Table S1. Screening of physical parameters tolerance of thraustochytrids cultures growth data (OD value) for 24 and 96 h.
Statements
Data availability statement
The datasets presented in this study can be found in online repositories. The names of the repository/repositories and accession number(s) can be found below: https://www.ncbi.nlm.nih.gov/, KT716335.1 https://www.ncbi.nlm.nih.gov/, KT716337.1.
Author contributions
KalK designed the study, performed the laboratory experiments, prepared the draft, performed the data analysis, and completed the writing – review & editing the manuscript. VV, and SC designed the study, supervised the work, reviewed, edited, and approved the manuscript. PM performed the laboratory experiments and performed the data analysis. NK reviewed, edited, and approved the manuscript. KatK, and YT helped to design the study, reviewed, and edited the manuscript. All authors contributed to the article and approved the submitted version.
Funding
This work was supported by Second Century Fund (C2F) Postdoctoral Scholarship of Chulalongkorn University, NRCT-JSPS Core to Core Program, CREPSUM JPJSCCB20200009, Thailand Science Research and Innovation Fund Chulalongkorn University (CU_FRB65_dis (3)_091_23_21)), National Research Council of Thailand and Chulalongkorn University (N42A650257), Thailand Science research and Innovation Fund Chulalongkorn University (DIS66230010), and Mubadala Petroleum (Thailand) Limited. Mubadala Petrolem (Thailand) was not involved in the study design, collection analysis, interpretation of data, the writing of this article or the decision to submit it for publication.
Acknowledgments
The authors are thankful to Second Century Fund (C2F) for postdoctoral fellowship and to the authorities of Chulalongkorn University, Thailand.
Conflict of interest
The authors declare that the research was conducted in the absence of any commercial or financial relationships that could be construed as a potential conflict of interest.
Publisher’s note
All claims expressed in this article are solely those of the authors and do not necessarily represent those of their affiliated organizations, or those of the publisher, the editors and the reviewers. Any product that may be evaluated in this article, or claim that may be made by its manufacturer, is not guaranteed or endorsed by the publisher.
Supplementary material
The Supplementary Material for this article can be found online at: https://www.frontiersin.org/articles/10.3389/fmars.2023.1126452/full#supplementary-material
References
1
Aasen I. M. Ertesvag H. Heggeset T. M. B. Liu B. Brautaset T. Vadstein O. (2016). Thraustochytrids as production organisms for docosahexaenoic acid (DHA), sqalene, and carotenoids. Appl. Microbiol. Biotechnol.100 (10), 4309–4321. doi: 10.1007/s00253-016-7498-4
2
Abad X. Turon X. (2015). Biotechnological production of docosahexaenoic acid using Aurantiocytrium limacinum: Carbon sources comparison and growth characterization. Mar. Drugs13, 7275–7284. doi: 10.3390/md13127064
3
Aini U. N. Lunprom S. Reungsang A. Salakkam A. (2022). Docosahexaenoic acid (DHA) production by Aurantiochytrium limacinum using cassava pulp hydrolysate as an alternative low-cost carbon source. Front. Mar. Sci.9. doi: 10.3389/fmars.2022.985119
4
Barclay W. Zeller S. (1996). Nutritional enhancement of n-3 and n-6 fatty acids in rotifers and arteia nauplii by feeding spray-dried Schizochytrium sp. J. Wor. Aqua. Soc27 (3), 314–322. doi: 10.1111/j.1749-7345.1996.tb00614.x
5
Bongiorni L. (20122012). Progress in molecular and subcellular biology Vol. 53 (Berlin/Heidelberg, Germany: Springer), ISBN: ISBN 3642233414.
6
Bowles R. D. Hunt A. E. Bremer G. B. Duchars M. G. Eaton R. A. (1999). Long-chain n-3 polyunsaturated fatty acid production by members of the marine protistan group the thraustochytrids: screening the isolates and optimization of DHA production. J. Biotechnol.70, 193–202. doi: 10.1016/S0168-1656(99)00072-3
7
Boyer-Diaz Z. Morata P. Aristu-Zabalza P. Gibert-Ramos A. Bosch J. Gracia-Sancho J. (2020). Oxidative stress in chronic liver disease and portal hypertension: Potential of DHA as nutraceutical. Nutrients12 (9), 2627. doi: 10.3390/nu12092627
8
Caamano E. Loperena L. Hinzpeter I. Pradel P. Gordillo F. Corsini G. et al . (2017). Isolation and molecular characterization of Thraustochytrium strain isolated from Antarctic peninsula and its biotechnological potential in the production of fatty acids. Braz. J. Microbiolo.48, 671–679. doi: 10.1016/j.bjm.2017.01.011
9
Castillo C. E. Gapasin R. S. Leano E. M. (2009). Enrichment potential of HUFA-rich thraustochytrid Schizochytrium mangrovei for the rotifer Brachionus plicatilis. Aqua293 (1-2), 57–61. doi: 10.1016/j.aquaculture.2009.04.008
10
Chang K. J. L. Nichols C. M. Blackburn S. I. Dunstan G. A. Koutoulis A. Nichols P. D. (2014). Comparison of thraustochytrids Aurantiochytrium sp., Schizochytrium sp., Thraustochytrium sp. and Ulkenia sp. for production of biodiesel, long–chain omega-3 oils, and exopolysaccharide. Mar. Biotechnol.16, 396–411. doi: 10.1007/s10126-014-9560-5
11
Chauhan A. S. Patel A. K. Chen C. W. Chang J. S. Michaud P. Dong C. D. et al . (2023). Enhanced production of high-value polyunsaturated fatty acids (PUFAs) from potential thraustochytrid Aurantiochytrium sp. Biores. Tech.370, 128536. doi: 10.1016/j.biortech.2022.128536
12
Dellero Y. Cagnac O. Rose S. Seddiki K. Cussac M. Morabito C. et al . (2018). Proposal of a new thraustochytrid genus Hondaea gen. nov. and comparison of its lipid dynamics with the closely related pseudo-cryptic genus Aurantiochytrium. Algal Res.35, 125–141. doi: 10.1016/j.algal.2018.08.018
13
Desbois A. P. Lawlor A. C. (2013). Antibacterial activity of long-chain polyunsaturated fatty acids against propionibacterium acnes and staphylococcus aureus. Mar. Drugs11, 4544–4557. doi: 10.3390/md11114544
14
Dholakiya R. N. Kumar R. Mishra A. Mody K. H. Jha B. (2017). Antibacterial and antioxidant activities of novel Actinobacteria strain isolated from gulf of khambhat, Gujarat. Front. Microbiol.7 (8). doi: 10.3389/fmich.2017.02420
15
Duan X. J. Zhang W. W. Li X. M. Wang B. G. (2006). Evaluation of antioxidant property of extract and fractions obtained from a red alga, Polysiphonia urceolata. Food Chem.95, 37–43. doi: 10.1016/j.foodchem.2004.12.015
16
Folch J. Lees M. Sloane Stanley G. H. (1957). A simple method for the isolation and purification of the total lipids from animal tissues. J. Biol. Chem.226, 497–509. doi: 10.1016/S0021-9258(18)64849-5
17
Gaffney M. O’Rourke R. Murphy R. (2014). Manipulation of fatty acid and antioxidant profiles of the microalgae Schizochytrium sp. through flaxseed oil supplementation. Algal Res.6, 195–200. doi: 10.1016/j.algal.2014.03.005
18
Govindarajan R. Rastogi S. Vijayakumar M. Rawat A. K. S. Shirwaikar A. Mehrotra S. et al . (2003). Studies on antioxidant activities of Desmodium gangetium. Biol. Pharmaceu. Bull.26, 1424–1427. doi: 10.1248/bpb.26.1424
19
Guedes A. C. Amaro H. M. Barbosa C. R. Pereira R. D. Malcata F. X. (2011). Fatty acid composition of several wild microalgae and cyanobacteria, with a focus on eicosapentaenoic, docosahexaenoic and linolenic acids for eventual dietary uses. Food Res. Internat.44, 2721–2729. doi: 10.1016/j.foodres.2011.05.020
20
Hamamoto Y. Honda. D. (2019). Nutritional intake of Aplanochytrium (Labyrinthulea, stramenopiles) from living diatoms revealed by culture experiments suggesting the new prey– predator interactions in the grazing food web of the marine ecosystem. PloS One14 (1), 208941. doi: 10.1371/journal.pone.0208941
21
Heggeset T. Ertesvåg H. Liu B. Ellingsen T. E. Vadstein O. Aasen I. M. (2019). Lipid and DHA-production in Aurantiochytrium sp. responses to nitrogen starvation and oxygen limitation revealed by analyses of production kinetics and global transcriptomes. Sci. Rep.9, 1–3. doi: 10.1038/s41598-019-55902-4
22
Hien H. T. M. Thom L. T. Ha N. C. Tam L. T. Thu N. Y. H. Nguyen T. V. et al . (2022). Characterization and optimization of culture conditions for aurantiochytrium sp. SC145 isolated from sand cay (Son Ca) island, Vietnam, and antioxidative and neuroprotective activities of its polyunsaturated fatty acids mixture. Mar. Drugs20 (12), 780. doi: 10.3390/md20120780
23
Honda D. Yokochi T. Nakahara T. Raghukumar S. Nakagiri A. Schaumann K. et al . (1999). Molecular phylogeny of labyrinthulids and thraustochytrids based on the sequencing of 18S ribosomal RNA gene. J. Eukaryot. Microbiol.46, 637–647. doi: 10.1111/j.15507408.1999.tb05141.x
24
Huang J. Aki T. Yokochi T. Nakahara T. Honda D. Kawamoto S. et al . (2003). Grouping newly isolated docosahexaenoic acid-producing thraustochytrids based on their polyunsaturated fatty acid profiles and comparative analysis of 18S rRNA genes. Mar. Biotechnol.5, 450–457. doi: 10.1007/s10126-002-0110-1
25
Huang C. B. Ebersole J. L. (2010). A novel bioactivity of omega-3 polyunsaturated fatty acids and their ester derivatives. Mol. Oral. Microbiol.25, 75–80. doi: 10.1111/j.2041-1014.2009.00553.x
26
Iwata I. Honda D. (2018). Nutritional intake by ectoplasmic nets of Schizochytrium aggregatum (Labyrinthulomycetes, stramenopiles). Protist169 (5), 727–743. doi: 10.1016/j.protis.2018.06.002
27
Jain R. Raghukumar S. Sambaiah K. Kumon Y. Nakahara T. (2007). Docosahexaenoic acid accumulation in thraustochytrids: search for the rational. Mar. Bio.151, 1657–1664. doi: 10.1007/s00227-007-0608-1
28
Jaseera K. V. Kaladharan P. Vijayan K. K. Sandhya S. V. Leo Antony M. Pradeep M. A. (2018). Isolation and phylogenetic identification of heterotrophic thraustochytrids from mangrove habitats along the southwest coast of India and prospecting their PUFA accumulation. J. Appl. Phycolo.31, 1057–1068. doi: 10.1007/s10811-018-1627-7
29
Kabilan C. Roy R. K. Chadha A. (2018). Docosahexaenoic acid production by a novel high yielding strain of Thraustochytrium sp. of Indian origin: Isolation and bioprocess optimization studies. Algal Res.32, 93–100. doi: 10.1016/j.algal.2018.03.011
30
Kalidasan K. Asmathunisha N. Gomathi V. Dufossé L. Kathiresan K. (2021a). Isolation and optimization of culture conditions of Thraustochytrium kinnei for biomass production, nanoparticle synthesis, antioxidant and antimicrobial activities. J. Mar. Sci. Eng.9, 678. doi: 10.3390/jmse9060678
31
Kalidasan K. Dufossé L. Manivel G. Senthilraja P. Kathiresan K. (2022). Antioxidant and anti-colorectal cancer properties in methanolic extract of mangrove-derived Schizochytrium sp. J. Mar. Sci. Eng.10, 431. doi: 10.3390/jmse10030431
32
Kalidasan K. Phusit H. Kathiresan K. (2019). Enumeration of thraustochytrids in decomposing leaves of mangroves as influenced by physicochemical and microbial factors. J. Curr. Res. Env. App. Myco.9, 288–300. doi: 10.5943/cream/9/1/24
33
Kalidasan K. Ravi V. Sunil K. S. Maheshwaran M. L. Kathiresan K. (2014). Antimicrobial and anticoagulant activities of the spine of stingray Himantura imbricate. J. Coast. Life Med.2, 89–93. doi: 10.12980/jclm.3.2015j5-75
34
Kalidasan K. Sahu S. K. Kayalvizhi K. Kathiresan K. (2015a). PUFA-producing marine thraustochytrids: a potential source for antimicrobials. J. Coast. L. Medi.3, 848–851. doi: 10.12980/jclm.3.2015j5-75
35
Kalidasan K. Sunil K. S. Narendran R. Kathiresan K. (2015b). Antioxidant activity of mangrove derived marine thraustochytrids. Mycosphere6, 602–611. doi: 10.5943/mycosphere/6/5/9
36
Kalidasan K. Vinithkumar N. V. Peter D. M. Dharani G. Dufossé L. (2021b). Thraustochytrids of mangrove habitats from Andaman islands: Species diversity, PUFA profiles and biotechnological potential. Mar. Drugs19, 571. doi: 10.3390/md19100571
37
Kamlangdee N. Fan K. W. (2003). Polyunsaturated fatty acids production by Schizochytrium sp. isolated from mangrove, songklanakarin. J. Sci. Tech.25, 643–650.
38
Kashiwagi T. Meyer-Rochow V. B. Nishimura K. Eguchi E. (1997). Fatty acid composition and ultrastructure of photoreceptive membranes in the crayfish Procambarus clarkii under conditions of thermal and photic stress. J. Comp. Physiol.167, 1–8. doi: 10.1007/s003600050041
39
Kathiresan K. Saravanakumar K. Anburaj R. Gomathi V. Abirami G. Sahu S. K. et al . (2011). Microbial enzyme activity in decomposing leaves of mangroves. Bipubl. Com.2, 382–389.
40
Kathiresan K. Saravanakumar K. Mullai P. (2014). Bioaccumulation of trace elements by Avicennia marina. J. Coast. Life Med.2 (11), 888–894. doi: 10.12980/JCLM.2.2014JCLM-2014-0011
41
Kim D. O. Lee K. W. Lee H. J. Lee C. Y. (2002). Vitamin c equivalent antioxidant capacity (VCEAC) of phenolic phytochemicals. J. Agric. Food Chem.50, 3713–3717. doi: 10.1021/jf020071c
42
Kulkarni R. D. (1997). Principles of pharmacology in ayurveda (Mumbai: Ram Sangam Graphics).
43
Kumari S. Vira C. Lali A. M. Prakash G. (2020). Heterologous expression of a mutant orange gene from Brassica oleracea increases carotenoids and induces phenotypic changes in the microalga Chlamydomonas reinhardtii. Algal Res.47, 101871. doi: 10.1016/j.algal.2020.101871
44
Laddha H. Pawar P. R. Prakash G. (2021). Bioconversion of waste acid oil to docosahexaenoic acid by integration of “ex novo” and “de novo” fermentation in Aurantiochytrium limacinum. Biores. Tech.332, 125062. doi: 10.1016/j.biortech.2021.125062
45
Leander C. Porter D. (2001). The labyrinthulomycota is comprised of three distinct lineages. Mycologia93, 459–464. doi: 10.2307/3761732
46
Leano E. M. Gapasin R. S. J. Polohan B. Vrijmoed L. L. P. (2003). Growth and fatty acid production of thraustochytrids from panay mangroves, Philippines. Fung. Divers.12, 111–122. Available at: http://hdl.handle.net/10862/1969.
47
Leyton A. Flores L. Shene C. Chisti Y. Larama G. Asenjo J. A. et al . (2021). Antarctic Thraustochytrids as sources of carotenoids and high-value fatty acids. Mar. Drugs19, 386. doi: 10.3390/md19070386
48
Liang S. Yang X. Zhu X. Ibrar M. Liu L. Li S. et al . (2022). Metabolic engineering to improve docosahexaenoic acid production in marine protist Aurantiochytrium sp. by disrupting 2,4-Dienoyl-CoA reductase. Front. Mar. Sci.9. doi: 10.3389/fmars.2022.939716
49
Liao J. Xiong Q. Yin Y. Ling Z. Chen S. (2022). The effects of fish oil on cardiovascular diseases: Systematical evaluation and recent advance. Front. Cardiovasc. Med.8. doi: 10.3389/fcvm.2021.802306
50
Lin H. C. Li W. H. Chen C. C. Cheng T. H. Lan Y. H. Huang M. D. et al . (2020). Diverse enzymes with industrial applications in four thraustochytrid genera. J. Microbio.11. doi: 10.3389/fmicb.2020.573907
51
Marchan L. F. Lee Chang K. J. Nichols P. D. Mitchell W. J. Polglase J. L. Gutierrez T. (2018). Taxonomy, ecology and biotechnological applications of thraustochytrids; a review. Biotec. Advan.36, 26–46. doi: 10.1016/j.biotechadv.2017.09.003
52
Mariam O. Kareya M. S. Nesamma A. A. Jutur P. P. (2021). Delineating metabolomic changes in native isolate Aurantiochytrium for production of docosahexaenoic acid in presence of varying carbon substrates. Algal Res.55, 102285. doi: 10.1016/j.algal.2021.102285
53
Meir S. Kanner J. Akiri B. Hadas S. P. (1995). Determination and involvement of aqueous reducing compounds in oxidative defense systems of various senescing leaves. J. Agricul. Food Chem.43, 1813–1817. doi: 10.1021/jf00055a012
54
Mo C. Rinkevich B. (2001). A simple, reliable and fast protocol for thraustochytrid DNA extraction. Mar. Biotechn.3, 100–102. doi: 10.1007/s101260000069
55
Mohan B. Sen B. Wen S. Ye H. He Y. Zhang X. et al . (2022). Culturable diversity of tharustochytrids from coastal waters of qingdao and their fatty acids. Mar. Drugs20 (4), 229. doi: 10.3390/md20040229
56
Mozaffarian D. Wu J. H. (2011). Omega-3 fatty acids and cardiovascular disease effects on risk factors, molecular pathways, and clinical events. J. Am. Coll. Cardiol.58, 2047–2067. doi: 10.1016/j.jacc.2011.06.063
57
Narwal S. Thakur V. Sheoran S. (2014). Antioxidant activity and phenolic content of the Indian wheat varieties. J. Plant Biochem. Biotechnol.23, 11–17. doi: 10.1007/s13562-012-0179-1
58
Nichols P. D. Nichols C. A. M. (2008). Microbial signature lipid profiling and exopolysaccharides: Experiences initiated with professor David c white and transported to Tasmania, Australia. J. Microbiol. Methods74, 33–46. doi: 10.1016/j.mimet.2007.06.017
59
Paliwal C. Nesamma A. A. Jutur P. P. (2019). “Industrial scope with high-value biomolecules from microalgae,” in Sustainable downstream processing of microalgae for industrial application (CRC press) (London: Taylor and Francis group), 376. doi: 10.1201/9780429027970
60
Park H. Kwak M. Seo J. Ju J. Heo S. Park S. et al . (2018). Enhanced production of carotenoids using a thraustochytrid microalgal strain containing high levels of docosahexaenoic acid-rich oil. Bioproc. Biosyst. Eng.41 (9), 1355–1370. doi: 10.1007/s00449-018-1963-7
61
Patel A. Karageorgou D. Katapodis P. Sharma A. Rova U. Christakopoulos P. et al . (2021). Bioprospecting of thraustochytrids for omega-3 fatty acids: A sustainable approach to reduce dependency on animal sources. Trends Food Sci. Tech.115, 433–444. doi: 10.1016/j.tifs.2021.06.044
62
Pawar P. R. Velani S. Kumari S. Lali A. M. Prakash G. (2021). Isolation and optimization of a novel thraustochytrid strain for DHA rich and astaxanthin comprising biomass as aquafeed supplement. Biotech11, 71. doi: 10.1007/s13205-020-02616-4
63
Raghukumar S. (2002). Ecology of the marine protists, the labyrinthulomycetes (thraustochytrids and labyrinthulids). Eur. J. Protistolo.38, 127–145. doi: 10.1078/0932-4739-00832
64
Raghukumar S. (2008). Thraustochytrid marine protists: production of PUFAs and other emerging technologies. Mar. Biotechnol.10, 631–640. doi: 10.1007/s10126-008-9135-4
65
Raghukumar S. (2017). Fungi in coastal and oceanic marine ecosystems (Germany: Springer International Publishing AG). doi: 10.1007/978-3-319-54304-8
66
Ramos-Vega A. Rosales-Mendoza S. Bañuelos-Hernandez B. Angulo C. (2018). Prospects on the use of Schizochytrium sp. to develop oral vaccines. Front. Microbiol.9. doi: 10.3389/fmicb.2018.02506
67
Rathod J. P. Vira C. Lali A. M. Prakash G. (2020). Metabolic engineering of Chlamydomonas reinhardtii for enhanced β-carotene and lutein production. Appl. Biochem. Biotech.190 (4), 1457–1469. doi: 10.1007/s1210-019-03194-9
68
Ratledge C. (2004). Fatty acid biosynthesis in microorganisms being used for single cell oil production. Biochimie86 (11), 807–815. doi: 10.1016/j.biochi.2004.09.017
69
Russo G. L. Langellotti A. L. Blasco T. Oliviero M. Sacchi R. Masi P. (2021). Production of omega-3 oil by Aurantiochytrium mangrovei using spent osmotic solution from candied fruit industry as sole organic carbon source. Processes9, 1834. doi: 10.3390/pr9101834
70
Sahin D. Tas E. Altindag U. H. (2018). Enhancement of docosahexaenoic acid (DHA) production from Schizochytrium sp., S31 using different growth medium conditions. AMB. Expr8, 0540–0544. doi: 10.1186/s13568-018-0540-4
71
Saini R. K. Ravishankar G. A. Keum Y. S. (2023). Microalgae and thraustochytrids are sustainable sources of vegan EPA and DHA with commercial feasibility. Indian J. Microbio. doi: 10.1007/s12088-023-01059-8
72
Schmitz G. Ecker J. (2008). The opposing effects of n-3 and n-6 fatty acids. Prog. Lipid. Res.47, 147–155. doi: 10.1016/j.p;o[res.2007.12.004
73
Seedevi P. Sudharsan S. Kanagarajan U. Guptha S. Srinivasan A. Vairamani S. et al . (2013). Studies on pharmacological potential of the marine macro-alga, Gracilaria debilis (J agardh) from Tamil nadu coast of India. Asian J. Mar. Sci.1 (1), 34–338.
74
Shin S. Y. Bajpai V. K. Kim H. R. Kang S. C. (2007). Antibacterial activity of bioconverted eicosapentaenoic (EPA) and docosahexaenoic acid (DHA) against foodborne pathogenic bacteria. Int. J. Food Microbiol.113, 233–236. doi: 10.1016/j.ijfoodmicro.2006.05.020
75
Singh N. Rajini P. S. (2004). Free radical scavenging activity of an aqueous extract of potato peel. Food. Chem.85, 611–616. doi: 10.1016/j.foodchem.2003.07.003
76
Singleton V. L. Orthofer R. Lamuela-Raventos R. M. (1999). Analysis of total phenols and other oxidation substrates and antioxidant by means of folin-ciocalteu reagent. Method. Enzymol.299, 152–178. doi: 10.1016/S0076-6879(99)99017-1
77
Song M. Nishihara R. Wu K. Qian Z. R. Kim S. A. Sukawa Y. et al . (2015). Marine ω-3 polyunsaturated fatty acids and risk for colorectal cancer according to microsatellite instability. J. Nat. Cancer Inst.107 (4), 1–8. doi: 10.1093/jnci/djv007
78
Sprague M. Walton J. Campbell P. Strachan F. Dick J. Bell J. (2015). Replacement of fish oil with a DHA- rich algal meal derived from Schizochytrium sp., on the fatty acid and persistent organic pollutant levels in diets and flesh of Atlantic salmon (Salmo salar, l.) post-smolts. Food Chem.185, 413–421. doi: 10.1016/j.foodchem.2015.03.150
79
Stahl W. Sies H. (2005). Bioactivity and protective effects of natural carotenoids. Biochim. Biophys. Acta1740, 101–107. doi: 10.1016/j.bbadis.2004.12.006
80
Taoka Y. Nagano N. Okita Y. Izumida H. Sugimoto S. Hayashi M. (2009). Extracellular enzymes produced by marine eukaryotes, thraustochytrids. Biosci. Biotechnol. Biochem.73, 180–182. doi: 10.1271/bbb.80416
81
Taoka Y. Nagano N. Okito Y. Izumida H. (2017). Degradation of distillery less (shochu kasu) by cellulose-producing thraustochytrids. J. Oleo Sci.66, 31–40. doi: 10.5650/jos.ess16148
82
Thompson J. D. Higgins D. G. Gibson T. J. Clustal W. (1994). Improving the sensitivity of progressive multiple sequence alignment through sequence weighting, position-specific gap penalties and weight matrix choice. Nucleic Acids Res.22, 4673–4680. doi: 10.1093/nar/22.22.4673
83
Vazhappilly R. Chen F. (1998). Heterotrophic production potential of omega-3 polyunsaturated fatty acids by microalgae and algae-like microorganisms. Bot. Marina.41, 553–558. doi: 10.1515/botm.1998.41.1-6.553
84
Venuste M. Zhang X. Shoemaker C. F. (2013). Influence of enzymatic hydrolysis and enzyme type on the nutritional and antioxidant properties of pumpkin meal hydrolysates. Food. Funct.4, 811–820. doi: 10.1039/c3fo30347k
85
Vu M. T. Tran G. H. Nguyen T. T. O. Ha T. T. Dang D. H. Hoang T. M. H. et al . (2022). Secondary metabolites of marine microalga Schizochytrium limacinum. Chem. Natural Compounds58, 1177–1180. doi: 10.1007/s10600-022-03899-0
86
Wang F. Bi Y. Diao J. Lv M. Cui J. Chen L. et al . (2019). Metabolic engineering to enhance biosynthesis of both docosahexaenoic acid and odd-chain fatty acids in schizochytrium sp. S31. Biotechn Biofuels.12 (1), 1–14. doi: 10.1186/s13068-019-148-x
87
Ward O. P. Singh A. (2005). Omega-3/6 fatty acids: alternative sources of production. Process Biochem.40 , 3627–3652. doi: 10.1016/j.procbio.2005.02.020
88
Watanabe K. Arafiles K. H. V. Higashi R. Okamura Y. Tajima T. Matsumura Y. et al . (2018). Isolation of high carotenoid-producing aurantiochytrium sp. mutants and improvement of astaxanthin productivity using metabolic information. J. Oleo. Sci.67 (5), 571–578. doi: 10.5650/jos.ess17230
89
Xiao R. Xi Y. Mi L. Xiang L. Yanzhang W. Min C. et al . (2018). Investigation of composition, structure and bioactivity of extracellular polymeric substances from original and stress-induced strains of Thraustochytrium striatum. Carbohyd. Polyme.18, 01448617305216. doi: 10.1016/j.carbpol.2018.044.126
90
Xing R. Yu H. Liu S. Zhang W. (2005). Antioxidant activity of differently regioselective chitosan sulfates in vitro. Bio. Org. Med. Chem.13, 1387–1392. doi: 10.1016/j.bmc.2004.11.002
91
Yaguchi T. Tanaka S. Yokochi T. Nakahara T. Higashihara T. (1997). Production of high yields of docosahexaenoic acid by Schizochytrium sp. strain SR21. J. Am. Oil Chem. Soc.74, 1431–1434. doi: 10.1007/s11746-997-0249-z
92
Ye C. Qiao W. Yu X. (2015). Reconstruction and analysis of the genome-scale metabolic model of Schizochytrium limacinum SR21 for docosahexaenoic acid production. BMC Genomics16, 799. doi: 10.1186/s12864-015-2042-y
93
Yu J. H. Wang Y. Sun J. Bian F. Chen G. Zhang Y. et al . (2017). Antioxidant activity of alcohol aqueous extracts of Crypthecodinium cohnii and Schizochytrium sp. J. Zhejiang Univ-Sci. B. (Biomedici Biotechnol)18, 797–806. doi: 10.1631/jzus.B1600367
Summary
Keywords
mangroves, thraustochytrids, biomass, PUFA, astaxanthin, antimicrobial, antioxidant
Citation
Kaliyamoorthy K, Chavanich S, Kandasamy K, Ponnuvel M, Kamlangdee N, Taoka Y and Viyakarn V (2023) PUFA and carotenoid producing thraustochytrids and their anti-microbial and antioxidant activities. Front. Mar. Sci. 10:1126452. doi: 10.3389/fmars.2023.1126452
Received
17 December 2022
Accepted
17 March 2023
Published
10 May 2023
Volume
10 - 2023
Edited by
Sophia Letsiou, University of West Attica, Greece
Reviewed by
Esra Imamoglu, Ege University, Türkiye; Tonmoy Ghosh, Indian Institute of Technology Indore, India; Chetan Paliwal, Centrum Algatech, Czechia
Updates
Copyright
© 2023 Kaliyamoorthy, Chavanich, Kandasamy, Ponnuvel, Kamlangdee, Taoka and Viyakarn.
This is an open-access article distributed under the terms of the Creative Commons Attribution License (CC BY). The use, distribution or reproduction in other forums is permitted, provided the original author(s) and the copyright owner(s) are credited and that the original publication in this journal is cited, in accordance with accepted academic practice. No use, distribution or reproduction is permitted which does not comply with these terms.
*Correspondence: Voranop Viyakarn, Voranop.V@chula.ac.th; Kalidasan Kaliyamoorthy, marinedasan87@gmail.com
Disclaimer
All claims expressed in this article are solely those of the authors and do not necessarily represent those of their affiliated organizations, or those of the publisher, the editors and the reviewers. Any product that may be evaluated in this article or claim that may be made by its manufacturer is not guaranteed or endorsed by the publisher.